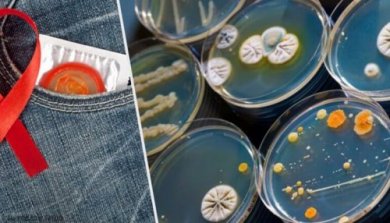

11 doenças sexualmente transmissíveis (DST) que você deve conhecer
As doenças sexualmente transmissíveis (DST), vulgarmente conhecidas como doenças venéreas, geralmente são adquiridas através do contato sexual com alguém infectado. Os organismos que causam essas doenças são transmitidos de pessoa para pessoa através de sangue, sêmen, fluidos vaginais e outros fluidos que emanam do corpo.
Além disso, essas doenças podem ser transmitidas de mãe para filho durante a gravidez ou no momento do parto. Além disso, por transfusões de sangue ou pelo uso de agulhas compartilhadas e contaminadas. Você pode obter essas doenças de pessoas aparentemente saudáveis, que podem ignorar que elas sofrem com elas, pois às vezes elas aparecem como assintomáticas.
A atividade sexual é um dos fatores que causam a disseminação de muitas infecções. Embora seja possível contrair uma infecção sem ter relações sexuais. Embora seja verdade que o uso de preservativos, ou preservativos de látex, reduza o risco de contrair e transmitir infecções ou doenças sexualmente transmissíveis, não evita completamente o risco de contágio.
Mesmo com os riscos envolvidos nas DST, muitas pessoas não tomam medidas de proteção. Para este mau hábito é adicionada a falta de informações sobre a maioria dessas doenças, sobre como elas são transmitidas e espalhadas.
Sintomas das DST

DST ou doenças venéreas causam uma série de sintomas ou sinais que às vezes podem passar despercebidos. Às vezes, a pessoa descobre que tem a doença só quando uma complicação surge ou seu parceiro é diagnosticado. Alguns dos sinais ou sintomas são:
- Feridas ou lesões nos órgãos genitais, reto e até mesmo a boca.
- Saída anormal no pênis.
- Ardor ou dor quando urina.
- Sangramento vaginal
- Dor ao fazer sexo.
- Descarga vaginal incomum com odor desagradável e amarelada.
- Erupção cutânea nos pés, nas mãos e no tronco.
- Dores abdominais
- Dor na virilha, à medida que os linfonodos se inflamam.
- Comichão, irritação, inflamação e dor no pênis, vagina, ânus e vulva.
- Irritação e dor nos órgãos genitais.
- Verrugas nos genitais.
- Parasitas.
- Febre
- Dor no corpo
- Manchas ou erupções na pele dos órgãos genitais ou em torno deles.
- Inflamação do fígado (hepatite A, B, C, D).
- Sangramento entre períodos ou após o sexo.
- Dor no abdômen inferior.
- Irritação da uretra (zona onde a urina sai).
Muitos desses sintomas podem ser causados por doenças que não sejam doenças sexualmente transmissíveis. Portanto, é necessário passar por um teste para saber com certeza qual é a condição. É importante enfatizar que esses sintomas podem aparecer após dias ou anos de contração da doença, depende de cada organismo.
Quando procurar o médico?
- Se você tem sinais ou sintomas de DST.
- Se você é uma pessoa sexualmente ativa e tem a suspeita de ter sido exposto a uma DST.
Causas de doenças sexualmente transmissíveis (DST)

As DSTs podem ser causadas por diferentes tipos de microrganismos, incluindo:
- Tricomoníase Parasitas : piolhos, sarna.
- Bactérias : gonorreia, clamídia, sífilis.
- Vírus : herpes genital, vírus da imunodeficiência humana (HIV), vírus do papiloma humano, hepatite B e C.
Quando as DSTs são causadas por parasitas e bactérias, elas podem ser tratadas com antibióticos ; mas quando são causados por vírus, eles não têm cura. Qualquer pessoa com vida sexual ativa não está isenta de contrair uma doença sexualmente transmissível, mas há fatores que aumentam essas possibilidades, tais como:
- Relações sexuais sem proteção. A penetração vaginal ou anal sem proteção com uma pessoa infectada aumenta o risco de contrair uma DST.
- Uso inadequado de preservativos.
- Sexo oral sem proteção de preservativo ou barreira.
- Relações sexuais com múltiplos parceiros.
- Ter sofrido de doenças sexualmente transmissíveis. Esta condição aumenta a chance de obter outra DST.
- Relações sexuais forçadas ou violação.
- Uso e abuso de álcool e drogas. Essas substâncias desinibem e podem levar a atividades de risco.
- Compartilhar agulhas aumenta a chance de contrair DST.
- Ser um adolescente. Nesta idade, o colo do útero é imaturo e consiste em células que estão mudando constantemente, o que torna o indivíduo mais vulnerável às DSTs.
Ações para reduzir o risco de contrair uma DST
- Em primeiro lugar, use preservativos
- Além disso, evite mudar os parceiros com frequência.
- Ademais, certifique-se de usar meios de proteção corretamente.
- Por outro lado, examine-se antes de fazer sexo com novos parceiros.
- Vacine-se.
- Não consuma álcool ou drogas.
- Também assegure uma boa comunicação. Fale com o parceiro antes de fazer sexo.
- Finalmente, tente se manter informado e informar os que te rodeiam.
Doenças sexualmente transmissíveis mais comuns (ETS)
1. Clamídia

É a doença bacteriológica mais comum. É transmitida através do sexo vaginal, oral e anal. Também ao compartilhar brinquedos sexuais ou de mãe a filho durante a gravidez ou o parto. Geralmente não tem sintomas e pode afetar as células do colo do útero, uretra, reto e às vezes os olhos e a garganta. Em alguns casos, causa esterilidade.
2. Gonorreia
Esta é uma infecção bacteriológica que se transmite sexualmente. Isso afeta a uretra, o colo do útero, o reto, o ânus e a garganta. Esta infecção pode causar sérios problemas para o bebê durante a gravidez. Além disso, pode causar esterilidade.
3. Sífilis
Esta é uma DST bacteriana altamente letal. Normalmente, é transmitida através do sexo vaginal, oral e anal. Mas também é compartilhado por brinquedos sexuais, por transfusão de sangue, pela mãe ao nascer, e pelo contato com a pele de uma pessoa com feridas causadas por sífilis.
4. Herpes genital

Esta DST é causada pelo vírus herpes simplex. É espalhado pelo contato direto da pele com a área infectada quando o sexo oral, vaginal e anal é praticado. Os sintomas desta doença podem aparecer anos após a contratação. Não tem cura, mas os sintomas podem ser tratados.
5. Vírus da imunodeficiência humana (HIV)
O vírus da imunodeficiência humana infecta e destrói as células do sistema imunológico, prejudicando a capacidade do organismo de se proteger contra infecções ou doenças como o câncer. Por exemplo, a forma de contraí-lo é através do sexo anal, vaginal e oral sem proteção, ou compartilhando seringas ou agulhas infectadas.
De forma semelhante, o contágio pode ocorrer da mãe para a criança no nascimento ou quando está amamentando o bebê, se a mãe estiver infectada. Além disso, existe o risco de transfusões de sangue. Não há cura para o HIV e isso implica uma alta probabilidade de desenvolver a Síndrome de Imunodeficiência Adquirida (AIDS).
6. Síndrome de Imunodeficiência Adquirida (AIDS)
A AIDS é o produto da infecção pelo vírus da imunodeficiência humana (HIV). Aids ataca o sistema imunológico do corpo. Geralmente, é transmitida pelo sexo vaginal, oral e anal. Muitas pessoas ficam infectadas e não apresentam sintomas, enquanto outras apresentam sintomas semelhantes aos da gripe.
Infelizmente, Aids é uma DST mortal e incurável. No entanto, medicamentos antivirais podem ser usados para neutralizar a doença e prolongar a vida e a saúde da pessoa infectada.
Confira também: A vacina contra o HIV / AIDS estará prestes a ser testada em milhares de pessoas
7. Tricomoníase

É uma DST bacteriana muito comum. Geralmente é transmitida através do contato sexual. Ele infecta as células da vagina e da uretra. Isso afeta principalmente mulheres jovens com vida sexual ativa. É transmitida por sexo vaginal, compartilhando brinquedos sexuais ou durante a gravidez para a criança. Às vezes, não tem sintomas.
8. Condilomas (HPV)
As verrugas genitais ou os condilomas são causados pelo vírus do papiloma humano (HPV). É transmitida através do sexo oral, vaginal e anal, bem como através do contato pele a pele com uma pessoa infectada. Aparecem verrugas nos genitais e no ânus. E quando não são tratadas, crescem e parecem uma couve-flor. Esta DST aumenta o risco de câncer no colo do útero.
Não há cura para o HPV, mas os condilomas podem ser tratados com medicamentos e às vezes removidos com procedimentos cirúrgicos.
9. Candidíase
É causada por um fungo que se hospeda na pele, boca e órgãos genitais. Além disso, ele pode ser mantido sob controle, mas às vezes este fungo cresce e produz esta doença. Muitas vezes não apresenta sintomas e é transmitida por contato sexual vaginal, anal e oral, além de compartilhar brinquedos sexuais.
Se você sofre desta DST, não é conveniente usar roupas apertadas feitas de materiais sintéticos que não favorecem a ventilação. A Candidíase aumenta o risco de gravidez, diabetes, HIV ou doenças que afetam o sistema imunológico.
Não deixe de ler: Tipos de herpes
10. Piolhos púbicos

Os piolhos púbicos são pequenos parasitas que aderem à pele e se alimentam de sangue. Eles vivem nos pelos, especialmente nos púbicos, embora às vezes eles possam permanecer nos pelos das axilas, face ou peito. Os caranguejos, como são comumente designados, são de cor cinza-amarela. Eles são facilmente transmitidos durante o sexo, mas também através de toalhas, roupa de cama e roupas.
Os sintomas são prurido ou inflamação da pele. Eles são removidos usando shampoo especial. Os lençóis, toalhas e roupas devem ser desinfetados.
11. Hepatite B
Esta doença é causada por um vírus perigoso que ataca o fígado. Além disso, é transmitida por sexo oral, anal e vaginal. Existem três tipos de hepatite: A, B e C. Por exemplo, todos podem ser transmitidos através do sexo, mas a hepatite B é a mais transmitida por esta via. Ademais, ela também pode ser transmitida através do sangue ao compartilhar agulhas e objetos contaminados.
A hepatite B ataca o fígado e pode causar cirrose, câncer de fígado, insuficiência hepática e possivelmente a morte. Não há cura para a hepatite B, mas a infecção pode ser tratada com medicamentos. Atualmente, existe uma vacina que aumenta a proteção contra esta doença.
Em conclusão, é essencial fazer exames médicos, especialmente quando você teve relações sexuais desprotegidas ou descobre que a outra pessoa tem doenças sexualmente transmissíveis (DST).
Todas as fontes citadas foram minuciosamente revisadas por nossa equipe para garantir sua qualidade, confiabilidade, atualidade e validade. A bibliografia deste artigo foi considerada confiável e precisa academicamente ou cientificamente.
- Sexually Transmitted Diseases (STDs). Centers for Disease Control and Prevention. https://www.cdc.gov/std/general/default.htm#:~:text=Human%20Papillomavirus%20(HPV)%20Infection,can%20be%20prevented%20with%20vaccines.
- What causes sexually transmitted diseases (STDs) or sexually transmitted infections (STIs)? National Institutes of Health. https://www.nichd.nih.gov/health/topics/stds/conditioninfo/causes
- Understanding Sexually Transmitted Disease Prevention. WebMD. https://www.webmd.com/sex-relationships/understanding-stds-prevention
- Enfermedades de transmisión sexual (ETS). Mayo Clinic. https://www.mayoclinic.org/es-es/diseases-conditions/sexually-transmitted-diseases-stds/symptoms-causes/syc-20351240
- VIH y sida. MedlinePlus. https://medlineplus.gov/spanish/hivaids.html
- Candidosis vaginal. MedlinePlus. https://medlineplus.gov/spanish/ency/article/001511.htm#:~:text=La%20mayor%C3%ADa%20de%20las%20mujeres,no%20ocasiona%20infecci%C3%B3n%20ni%20s%C3%ADntomas.
- Hepatitis B. MedlinePlus. https://medlineplus.gov/spanish/hepatitisb.html
Este texto é fornecido apenas para fins informativos e não substitui a consulta com um profissional. Em caso de dúvida, consulte o seu especialista.







